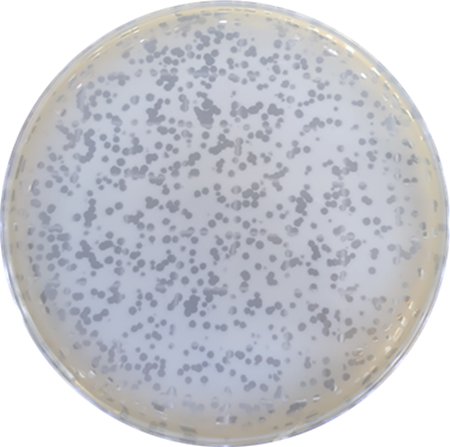
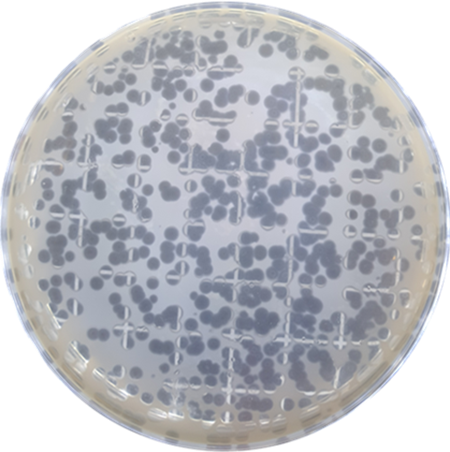
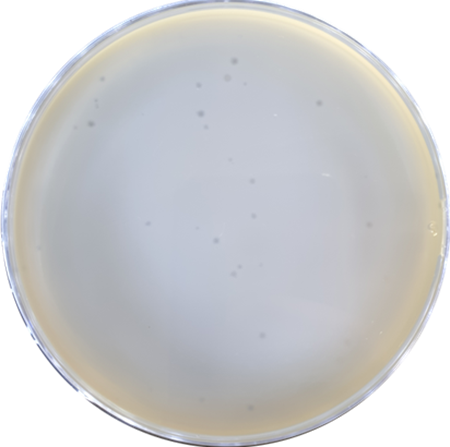

La première banque privée de phages en France
Pandora met à votre disposition une collection de phages utilisables pour vos projets de recherche, d’enseignement et vos applications industrielles.




Pandora est une collection de phages issue de la phagothèque de Leo viridis, filiale spécialisée en biotechnologies du groupe breton Tacthys. Fondée en 2019, la société investit sur le potentiel infini que présente le biomimétisme afin de développer et d’accompagner avec innovation les transformations industrielles. Depuis sa fondation, les travaux de l’entreprise ont porté sur le déploiement de ce potentiel grâce aux ressources biotechnologiques offertes par les microorganismes. D’entre eux tous, la bioprospection, l’étude et la valorisation des phages forment la clef de voûte de Leo viridis.
Les phages, une ressource biotechnologique d'avenir
Un phage est un virus qui cible uniquement les bactéries et les archées. Contrairement aux antibiotiques ou aux produits chimiques, dans un usage biotechnologique raisonné, il agit avec précision sans impacter négativement le reste de l’écosystème.

Infrastructures dédiées

Expertise scientifique

Démarche souveraine
Notre collection de phages
Chaque phage de notre banque est associé à son hôte spécifique. Explorez notre banque et sélectionnez les phages adaptés à vos besoins.
Un processus maîtrisé, du besoin à la livraison
Pandora garantit un process fiable et documenté, conforme aux exigences des laboratoires et industriels.
Expression du besoin
Vous nous transmettez votre demande, votre hôte bactérien cible ou votre cahier des charges. Nous analysons votre contexte scientifique pour déterminer la solution la plus adaptée : phage existant dans la collection ou besoin d’un isolement spécifique.
Analyse & cotation
Nos équipes étudient votre demande, vérifient la disponibilité des phages concernés et valident la faisabilité technique. Nous vous transmettons ensuite une cotation claire incluant délais, modalités logistiques et éventuelles options de caractérisation.
Recherche & production
Selon votre besoin, nous procédons à l’isolation du phage, à sa sanctuarisation puis à sa mise en isolement dans notre laboratoire interne. Les échantillons sont préparés en conditions contrôlées pour garantir qualité, stabilité et conformité scientifique.
Livraison & suivi
Les suspensions sont conditionnées sous chaîne du froid ou lyophilisées et expédiées conformément aux exigences logistiques. Après livraison, notre équipe reste disponible pour répondre à vos questions et vous accompagner dans l’utilisation ou la réplication du phage.
Besoin d’un phage spécifique ?
Si le phage que vous recherchez n’est pas encore disponible dans notre banque, nos équipes peuvent l’isoler, le caractériser et l'ingéniérer pour vous. Un service sur-mesure pour répondre aux besoins de vos projets scientifiques et industriels.
Nos valeurs et engagements
Parce que travailler avec des phages demande rigueur et transparence, nous avons structuré Pandora autour de principes clairs et mesurables.
Transparence scientifique
Chaque phage est livré avec ses données de base et peut être caractérisé davantage sur demande.
Réactivité garantie
Réponse sous 48h ouvrées à vos demandes et livraison de votre phage en 2 à 3 semaines.
Infrastructures dédiées
Nos phages sont isolés, caractérisés et conservés dans nos propres installations sécurisées, à Brest.
Accompagnement de l’innovation
Nos équipes sont là pour vous conseiller et vous accompagner dans le développement de votre biotechnologie.
Nos dernières publications scientifiques
Nous publions régulièrement nos avancées en matière de recherche et développement. Vous pouvez en apprendre plus sur nous et une partie de nos travaux de R&D à travers nos divers articles en ligne.
Des solutions biologiques sur mesure, à votre portée
Contactez notre équipe pour obtenir un devis, une bioprospection ou des informations sur nos phages disponibles.


















.png)
.png)

.png)







.jpg)








.png)

.png)

.png)
.png)
%203.webp)
%201.webp)